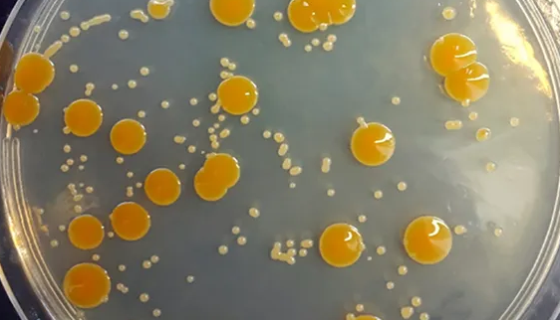
ATCC 29341 盐沼盐杆菌的菌株特点与保藏方法！

大肠杆菌的种类区别与特征特性及检测方法!
大肠杆菌(Escherichia coli),又叫大肠埃希氏...

副溶血性弧菌的生物学特性与微生物学检验方法!
副溶血性弧菌(Vibrio Parahemolyticus)...
ATCC 29341 盐沼盐杆菌的菌株特点与保藏方法!
盐沼盐杆菌是中国农业科学网收藏的一种非模式菌株。主要用途是研...

紫红曲霉的重要产物与发酵技术及培养方法!
紫红曲霉(Monascus purpureus)是一种腐生真...

MC38 小鼠结肠癌细胞的处理方法与培养步骤!
小鼠结肠癌细胞的处理方法与培养步骤及需要注意的事项有哪些?

ATCC 13312 肠炎沙门氏菌肠炎亚种的培养与使用!
肠炎沙门氏菌肠炎亚种的培养方法与使用范围及注意事项有哪些?

产黄青霉的培养方法与保藏条件及注意事项!
产黄青霉属无性型真菌,一种属于半知菌亚门丝孢纲丝孢目(从梗孢...

酿脓链球菌的形态特征与培养条件及安全须知!
酿脓链球菌(Streptococcus pyogenes),...

小鼠辅助性T细胞收到后处理方法与培养步骤!
小鼠辅助性T细胞收到后处理方法与培养步骤及注意事项有哪些?